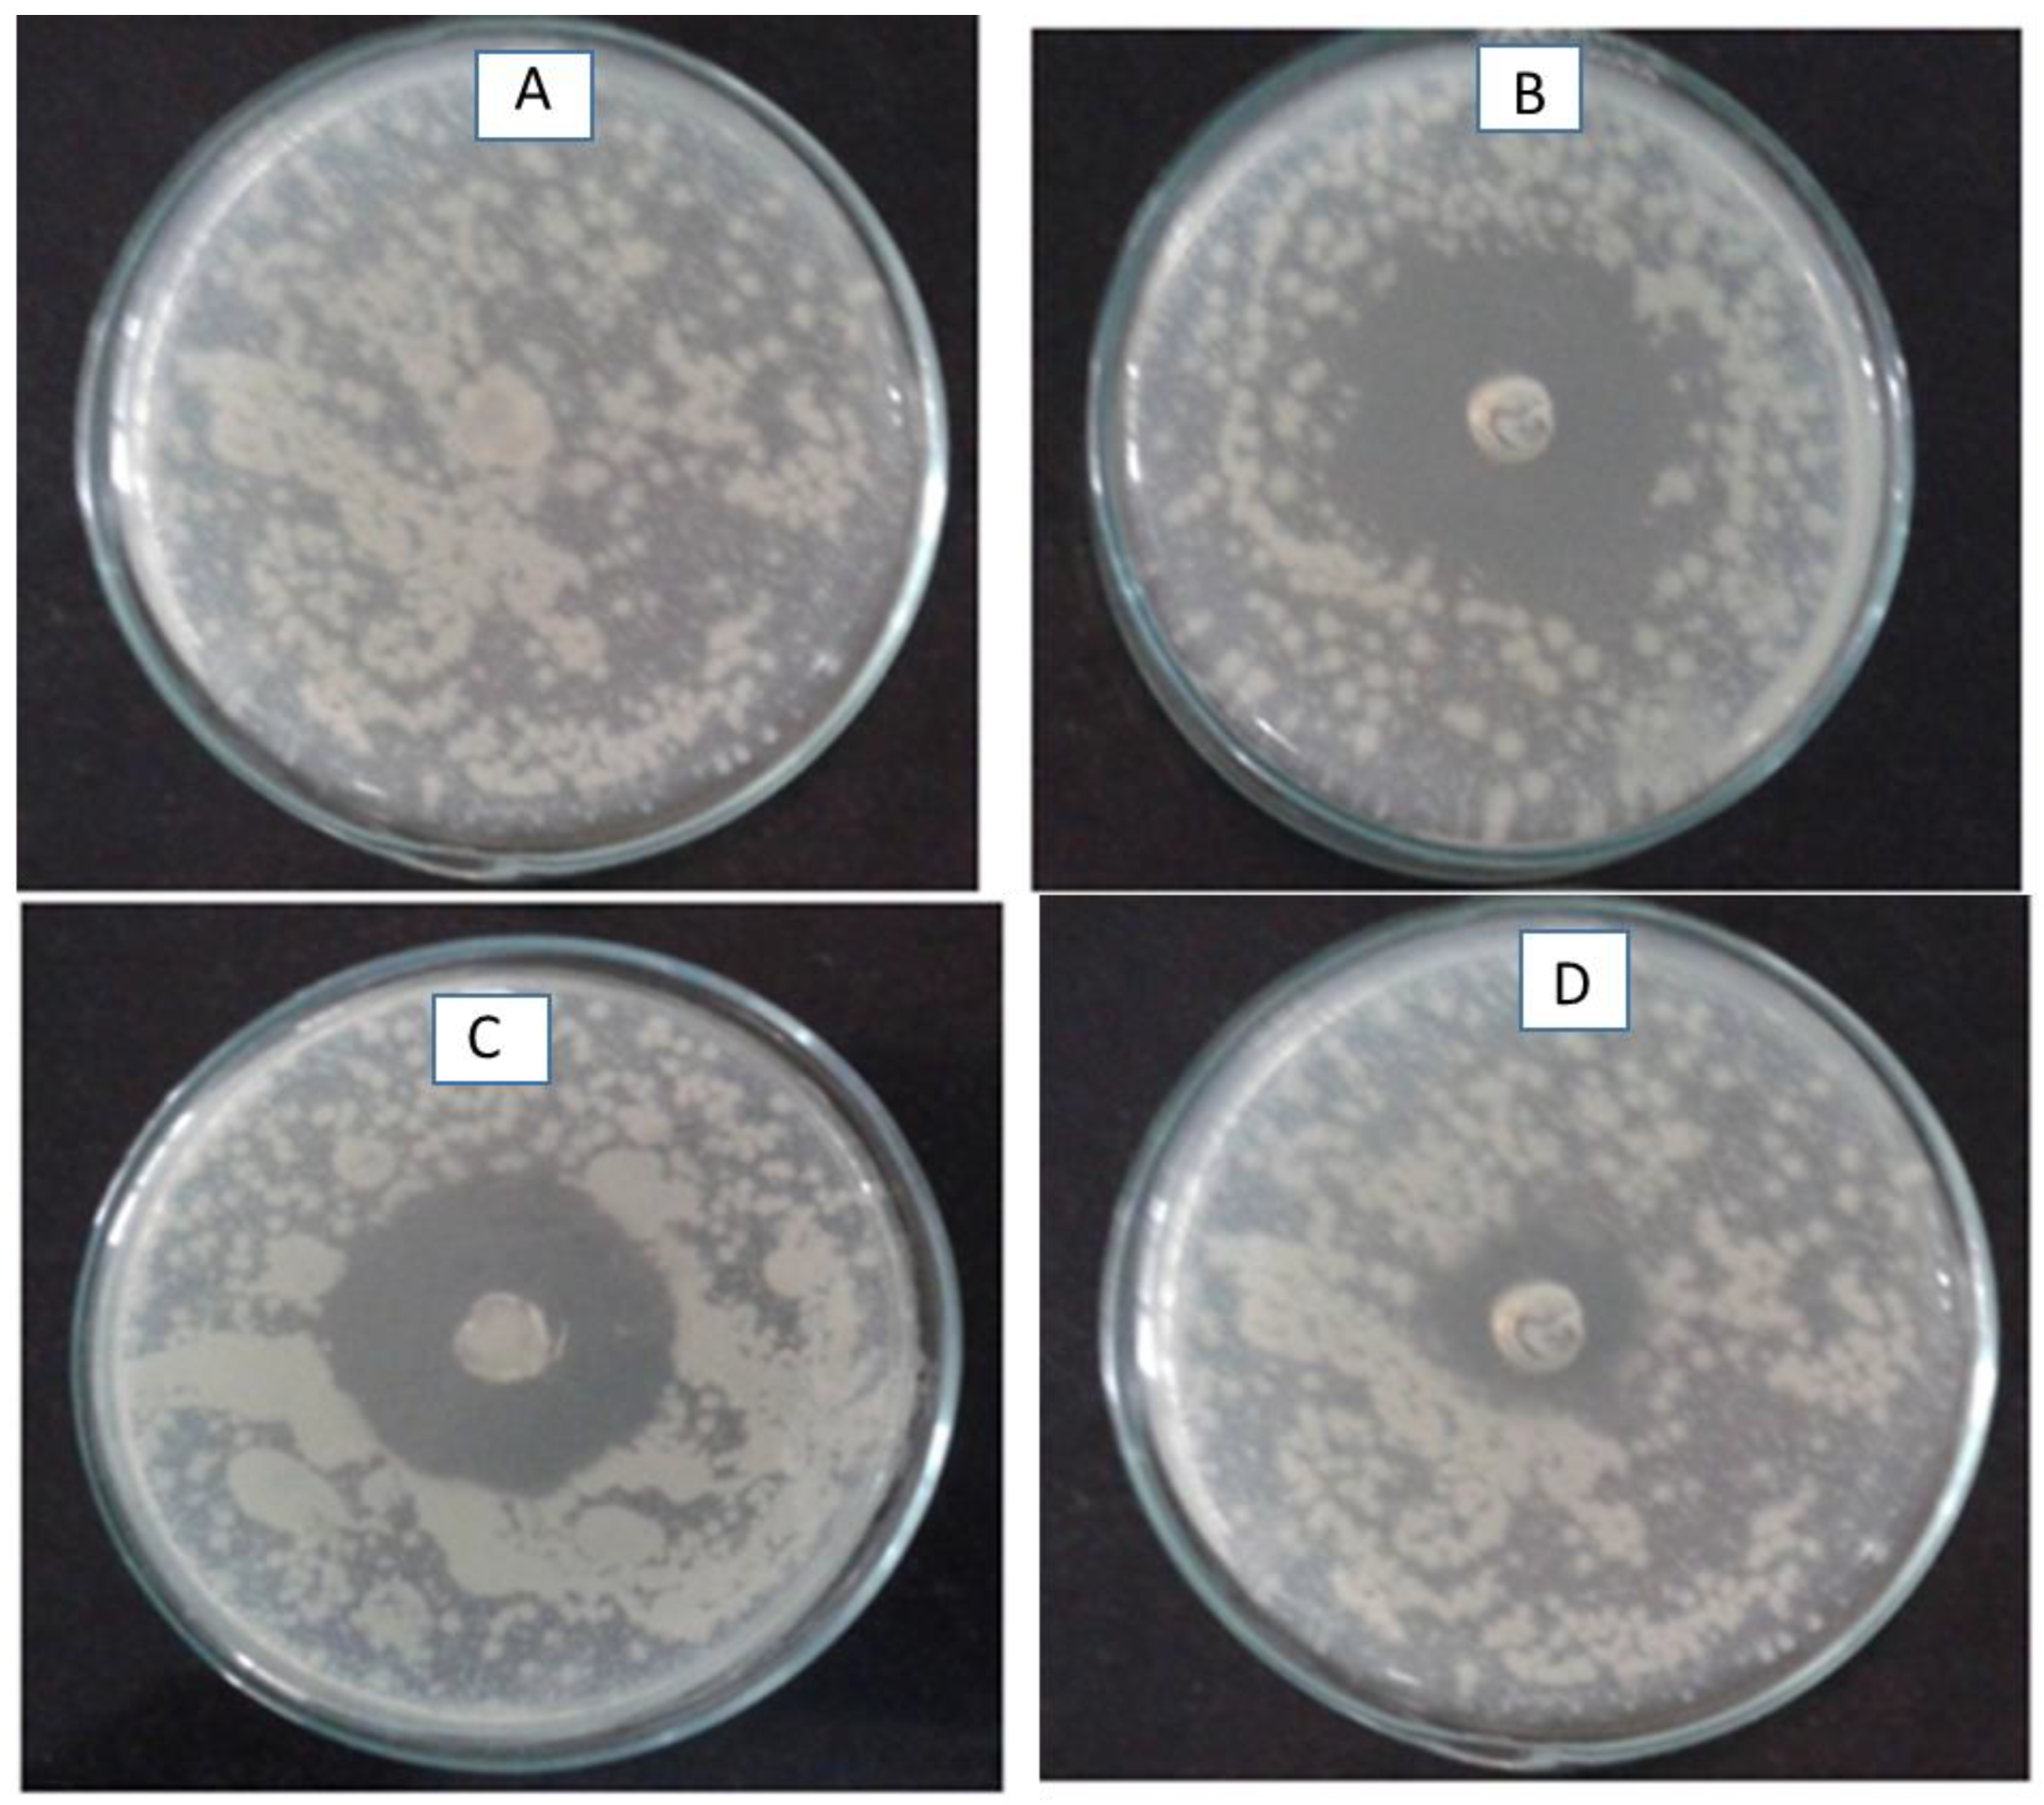

Development and In Vitro Characterization of Antibiotic-Loaded Nanocarriers for Dental Delivery
Abstract
1. Introduction
2. Results
2.1. Characterization
2.2. In Vitro Drug-Loading Studies
2.3. Drug Content of Plain Gel
2.4. In Vitro Drug Release
2.5. Anti-Bacterial Studies
2.6. Scanning Electron Microscopy
2.7. Differential Scanning Calorimetry (DSC)
2.8. Fourier Transform Infrared Spectroscopy (FTIR)
2.9. XRD-X-ray Diffraction
3. Discussion
4. Materials and Method
4.1. Extraction of Beta Tricalcium Phosphate from Coral Beach Sand by Using Hydrothermal Conversion Method
4.2. Preparation of Nanocarriers
Preparation of Plain Ciprofloxacin Hydrochloride Gel
4.3. Identification Tests for Beta-Tricalcium Phosphate
4.3.1. Identification Test for Phosphate
4.3.2. Identification Test for Calcium
4.4. Characterization
4.4.1. Micrometric Properties
Bulk Density
Tapped Density
Hausner’s Ratio
Carr’s Compressibility Index
Angle of Repose
4.4.2. In Vitro Drug-Loading Studies
4.4.3. Drug Content of Plain Gel
4.4.4. In Vitro Drug Release Studies
4.4.5. Anti-Microbial Studies
4.4.6. Scanning Electron Microscopy (SEM Studies)
4.4.7. Differential Scanning Calorimetry (DSC)
4.4.8. Fourier Transform Infrared (FTIR) Spectroscopy
4.4.9. XRD Studies (XRD)
4.5. Statistical Analysis
5. Conclusions
Author Contributions
Funding
Institutional Review Board Statement
Informed Consent Statement
Data Availability Statement
Acknowledgments
Conflicts of Interest
References
- U.S. Department of Health and Human Services. Human, Oral Health in America: A Report of the Surgeon General; NIH Publication: Washington, DC, USA, 2000; pp. 155–188.
- Liang, Y.; Luan, X.; Liu, X. Recent advances in periodontal regeneration: A biomaterial perspective. Bioact. Mater. 2020, 5, 297–308. [Google Scholar] [CrossRef]
- Graziani, F.; Karapetsa, D.; Alonso, B.; Herrera, D. Nonsurgical and surgical treatment of periodontitis: How many options for one disease? Periodontology 2017, 75, 152–188. [Google Scholar] [CrossRef] [PubMed]
- Smiley, C.J.; Tracy, S.L.; Abt, E.; Michalowicz, B.S.; John, M.T.; Gunsolley, J.; Cobb, C.M.; Rossmann, J.; Harrel, S.K.; Forrest, J.L.; et al. Evidence-based clinical practice guideline on the nonsurgical treatment of chronic periodontitis by means of scaling and root planning with or without adjuncts. J. Am. Dent. Assoc. 2015, 146, 525–535. [Google Scholar] [CrossRef]
- Villar, C.C.; Cochran, D.L. Regeneration of periodontal tissues: Guided tissue regeneration. Dent. Clin. 2010, 54, 73–92. [Google Scholar] [CrossRef] [PubMed]
- Kao, D.L.; Nares, S.; Reynolds, M.A. Periodontal regeneration-intrabony defects: Asystematic review from the AAP Regeneration Workshop. J. Periodontol. 2015, 86, S77–S104. [Google Scholar] [CrossRef] [PubMed]
- Lin, Z.; Rios, H.F.; Cochran, D.L. Emerging regenerative approaches for periodontal reconstruction: A systematic review from the AAP Regeneration Workshop. J. Periodontol. 2015, 86, S134–S152. [Google Scholar] [CrossRef] [PubMed]
- Li, F.; Yu, F.; Xu, X.; Li, C.; Huang, D.; Zhou, X.; Ye, L.; Zheng, L. Evaluation of recombinant human FGF-2 and PDGF-BB in periodontal regeneration: A systematic review and meta-analysis. Sci. Rep. 2017, 7, 65. [Google Scholar] [CrossRef]
- Aithal, G.C.; Nayak, U.Y.; Mehta, C.; Narayan, R.; Gopalkrishna, P.; Pandiyan, S.; Garg, S. Localized in situ nanoemulgel drug delivery system of quercetin for periodontitis: Development and computational simulations. Molecules 2018, 23, 1363. [Google Scholar] [CrossRef]
- Bejon, P.; Robinson, E. Bone and joint infection. Medicine 2013, 41, 719–722. [Google Scholar] [CrossRef]
- Manzano, M.; Vallet-Regí, M.A. Revisiting bioceramics: Bone regenerative and local drug delivery systems. Prog. Solid State Chem. 2012, 40, 17–30. [Google Scholar] [CrossRef]
- Topal, G.R.; Devrim, B.; Eryilmaz, M.; Bozkir, A. Design of ciprofloxacin-loaded nano-and micro-composite particles for dry powder inhaler formulations: Preparation, in vitro characterisation, and antimicro-bial efficacy. J. Microencapsul. 2018, 35, 533. [Google Scholar] [CrossRef]
- Arafa, M.G.; Mousa, H.A.; Afifi, N.N. Preparation of PLGA-chitosan based nanocarriers for enhancing anti-bacterial effect of ciprofloxacin in root canal infection. Drug Deliv. 2020, 27, 26. [Google Scholar] [CrossRef] [PubMed]
- Singh, K.P.; Chhabra, G.; Sharma, V.; Pathak, K. Thermosensitive periodontal sol of ciprofloxacin hydrochloride and serratiopeptidase: Pharmaceutical and mechanical analysis. Int. J Pharm. Investig. 2014, 4, 5–14. [Google Scholar] [PubMed]
- Zilberman, M.; Elsner, J.J. Antibiotic-eluting medical devices for various applications. J. Control. Release 2008, 130, 202–215. [Google Scholar] [CrossRef]
- Albuquerque, M.T.; Valera, M.C.; Moreira, C.S.; Bresciani, E.; de Melo, R.M.; Bottino, M.C. Effects of ciprof-loxacin-containing scaffolds on Enterococcus faecalis biofilms. J. Endod. 2015, 41, 710. [Google Scholar] [CrossRef] [PubMed]
- Barbotteau, Y.; Irigaray, J.L.; Mathiot, J.F. Modelling by percolation theory of the behavior of natural coral used as bone substitute. Phys. Med. Biol. 2003, 48, 3611–3623. [Google Scholar] [CrossRef]
- Roy, D.M.; Linnehan, S.K. Hydroxyapatite formed from coral skeletal carbonate by hydrothermal exchange. Nature 1974, 247, 220–222. [Google Scholar] [CrossRef]
- Chou, J.; Ben-Nissan, B.; Choi, A.H.; Wuhrer, R.; Green, D. Conversion of coral sand to calcium phosphate for biomedical application. J. Aust. Ceram. Soc. 2007, 43, 44–48. [Google Scholar]
- Chattopadhyay, P.; Pal, S.; Wahi, A.K.; Singh, L.; Verma, A. Synthesis of crystalline hydroxyapetite from coral (Gergonacea sp) and cytotoxicity evaluation. Trends Biomater. Artif. 2007, 20, 139–142. [Google Scholar]
- Gupta, P.; Gupta, V.; Jain, A.; Khan, S.; Raza, K. Mucoadhesive gel containing chlorhexidine for local drug delivery: Development and characterization. J. Drug Deliv. Sci. Technol. 2014, 24, 666–672. [Google Scholar]
- Suresh, P.; Chandrasekaran, S.C.; Sivakumar, M.; Kaviyarasan, V. Formulation and evaluation of mucoadhesive gel containing ciprofloxacin for dental application. J. Appl. Pharm. Sci. 2013, 3, 47–54. [Google Scholar]
- Samiei, M.; Faridi-Majidi, R.; Behzadi, S. Nanofiber-based local drug delivery systems for oral and dental applications: A review. Acta Biomater. Odontol. Scand. 2016, 2, 19–29. [Google Scholar]
- Muthu, J.; Gopal, J.; Ramasamy, M. In vitro release kinetics of ciprofloxacin hydrochloride from nanogel system: A new therapeutic approach for periodontitis. J. Pharm. Bioallied. Sci. 2013, 5 (Suppl. S1), S35–S39. [Google Scholar]
- Duan, R.; Liu, Y.; Yan, J.; Ding, M.; Han, Y.; Lu, W. Nanoemulsion-based local drug delivery system for the treatment of dental caries. J. Dent. Sci. 2021, 16, 600–606. [Google Scholar]
- Ruiz-Aguilar, C.; Olivares-Pinto, U.; Aguilar-Reyes, E.A.; López-Juárez, R.; Alfonso, I. Characterization of β-tricalcium phosphate powders synthesized by sol–gel and mechanosynthesis. Bol. Soc. Esp. Ceram. Vidr. 2018, 57, 213–220. [Google Scholar] [CrossRef]
- Southard, G.L.; Godowaski, K.C. Subgingival controlled release of antimicrobial agent in the treatment of periodontal disease. Int. J. Antimicrob. Agents 1998, 9, 239–253. [Google Scholar] [CrossRef] [PubMed]
- Shinde, U.; Pokharkar, S.; Madani, S. Design and evaluation of microemulsion gel system of nadifloxacin. Ind. J. Pharm. Sci. 2012, 74, 237. [Google Scholar] [CrossRef]
- Aharshikhashiny, T.; Manicharan, D.; Rajeshri, D. Enhanced dermal delivery of nadifloxacin using liposomes. Int. J. Appl. Pharm. 2016, 8, 53–59. [Google Scholar]
- Nithya, R.; Meenakshi Sundaram, N. Biodegradation and cytotoxicity of ciprofloxacin loaded hydroxyapatite polycaprolactonenanocomposite film for sustainable bone implants. Int. J. Nanomed. 2015, 10, 119–127. [Google Scholar]

| Test | Observation | Inference | |
|---|---|---|---|
| 1 | Test for phosphate | Yellow precipitate was observed | Yellow precipitate was formed |
| 2 | Flame test for calcium | Responds to flame test | Ash was formed |
| 3 | Test for calcium | White precipitate was observed | White precipitate was formed |
| Formulation Code | Angle of Repose (θ°) Mean ± SD * | Tapped Density (g/cm3) Mean ± SD * | Bulk Density (g/cm3) Mean ± SD * | Carr’s Index (%) Mean ± SD * | Hausner’s Ratio Mean ± SD * |
|---|---|---|---|---|---|
| F1 | 36 ± 1.8 | 0.78 ± 0.02 | 0.66 ± 0.09 | 15.55 ± 1.2 | 1.196 ± 0.25 |
| F2 | 46 ± 0.89 | 0.96 ± 0.78 | 0.78 ± 0.98 | 15.59 ± 0.74 | 1.8 ± 0.85 |
| F3 | 51 ± 0.76 | 0.84 ± 0.98 | 0.89 ± 0.66 | 37.09 ± 0.76 | 1.58 ± 0.34 |
| F4 | 43 ± 0.45 | 0.54 ± 0.76 | 0.75 ± 0.90 | 28 ± 0.97 | 1.72 ± 0.56 |
| F5 | 54 ± 0.78 | 0.53 ± 0.49 | 0.68 ± 0.81 | 45.01 ± 0.87 | 1.98 ± 0.71 |
| F6 | 45 ± 0.69 | 0.95 ± 0.89 | 0.92 ± 0.29 | 26.86 ± 0.65 | 1.36 ± 0.69 |
| F7 | 52 ± 0.97 | 0.82 ± 0.16 | 0.67 ± 0.99 | 30.09 ± 0.64 | 1.78 ± 0.6 |
| F8 | 48 ± 0.5 | 0.73 ± 0.89 | 0.8 ± 0.56 | 18 ± 0.16 | 1.2 ± 0.4 |
| F9 | 54 ± 0.32 | 0.79 ± 0.95 | 0.77 ± 0.78 | 17.01 ± 0.27 | 1.85 ± 0.13 |
| F10 | 45 ± 0.31 | 0.88 ± 0.67 | 0.80 ± 0.18 | 26.86 ± 0.82 | 1.6 ± 0.93 |
| Formulation | Ratio (Drug and Carrier) | Drug (mg) | β-TCP (mg) | 6.8 pH Phosphate Buffer Saline Solution (mL) |
|---|---|---|---|---|
| F1 | 1:1 | 500 | 500 | 75 |
| F2 | 1:1 | 500 | 500 | 100 |
| F3 | 1:1 | 500 | 500 | 150 |
| F4 | 1:1 | 500 | 500 | 200 |
| F5 | 1:2 | 125 | 250 | 75 |
| F6 | 2:1 | 250 | 125 | 75 |
| F7 | 1:3 | 125 | 375 | 75 |
| F8 | 1:4 | 125 | 500 | 75 |
| F9 | 3:1 | 375 | 125 | 75 |
| F10 | 4:1 | 500 | 125 | 75 |
Disclaimer/Publisher’s Note: The statements, opinions and data contained in all publications are solely those of the individual author(s) and contributor(s) and not of MDPI and/or the editor(s). MDPI and/or the editor(s) disclaim responsibility for any injury to people or property resulting from any ideas, methods, instructions or products referred to in the content. |
© 2023 by the authors. Licensee MDPI, Basel, Switzerland. This article is an open access article distributed under the terms and conditions of the Creative Commons Attribution (CC BY) license (https://creativecommons.org/licenses/by/4.0/).
Share and Cite
Ghazwani, M.; Vasudevan, R.; Kandasamy, G.; Hani, U.; Niharika, G.; Naredla, M.; Devanandan, P.; Puvvada, R.C.; Almehizia, A.A.; Hakami, A.R.; et al. Development and In Vitro Characterization of Antibiotic-Loaded Nanocarriers for Dental Delivery. Molecules 2023, 28, 2914. https://doi.org/10.3390/molecules28072914
Ghazwani M, Vasudevan R, Kandasamy G, Hani U, Niharika G, Naredla M, Devanandan P, Puvvada RC, Almehizia AA, Hakami AR, et al. Development and In Vitro Characterization of Antibiotic-Loaded Nanocarriers for Dental Delivery. Molecules. 2023; 28(7):2914. https://doi.org/10.3390/molecules28072914
Chicago/Turabian StyleGhazwani, Mohammed, Rajalakshimi Vasudevan, Geetha Kandasamy, Umme Hani, Gaddam Niharika, Manusri Naredla, Praveen Devanandan, Ranadheer Chowdary Puvvada, Abdulrahman A. Almehizia, Abdulrahim R. Hakami, and et al. 2023. "Development and In Vitro Characterization of Antibiotic-Loaded Nanocarriers for Dental Delivery" Molecules 28, no. 7: 2914. https://doi.org/10.3390/molecules28072914
APA StyleGhazwani, M., Vasudevan, R., Kandasamy, G., Hani, U., Niharika, G., Naredla, M., Devanandan, P., Puvvada, R. C., Almehizia, A. A., Hakami, A. R., & Dhurke, R. (2023). Development and In Vitro Characterization of Antibiotic-Loaded Nanocarriers for Dental Delivery. Molecules, 28(7), 2914. https://doi.org/10.3390/molecules28072914

